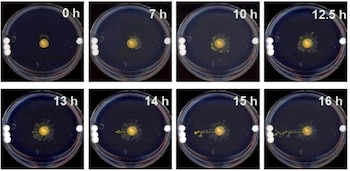
Esta serie de fotografías de

Un nuevo descubrimiento hecho por los científicos del Instituto Wyss de la Universidad de Harvard y del Centro de Descubrimiento Allen de la Universidad de Tufts (EE.UU.) encontró que el moho de lodo o “Physarum Polycephalum”, un organismo que no posee cerebro ni sistema nervioso, es capaz de “pensar” usando su cuerpo para detectar señales mecánicas en su entorno, realizar cálculos y decidir hacia qué dirección crecer.
“La gente se está interesando más en Physarum porque no tiene cerebro, pero aún puede realizar muchos de los comportamientos que asociamos con el pensamiento”, dijo la neurocientífica Nirosha Murugan de la Universidad de Algoma en Canadá.
“Averiguar cómo la vida protointeligente se las arregla para hacer este tipo de cálculo nos da más información sobre los fundamentos de la cognición y el comportamiento de los animales, incluido el nuestro”, agregó.
Estas capacidades del moho del lodo tiene completamente asombrados e interesados a los científicos pues nunca antes las habían observado en organismos similares.
P. polycephalum es un pequeño organismo curioso. En realidad, no es un hongo en absoluto; ni es un animal o una planta. Pertenece al reino protista, básicamente cualquier cosa que no pertenezca a los otros tres reinos. Vive en ambientes oscuros y húmedos como los suelos de los bosques, lo que ayuda en la descomposición de la materia orgánica y la recicla de nuevo en la red alimentaria.
Este organismo comienza su vida como muchas células individuales, cada una con su propio núcleo. Estas células se fusionan para formar el plasmodio, una gran célula única que contiene millones o incluso miles de millones de núcleos que nadan en un líquido citoplasmático. Ésta es la etapa vegetativa de la vida, en la que el protista se mueve, se alimenta y crece.
También es la etapa en la que P. polycephalum exhibe algunos comportamientos curiosos. Los científicos lo han observado resolviendo laberintos y recordando nuevas sustancias durante meses. También puede recordar lugares en los que anteriormente encontró comida y compartir recuerdos con otras manchas de moho, lo que es bastante increíble para algo que no tiene cerebro ni sistema nervioso.
La mayor parte de la investigación anterior ha implicado algún tipo de incentivo, como una sustancia química que no le gustó al protista, la luz o una recompensa alimentaria. Muruga y su equipo querían saber cómo P. polycephalum toma decisiones en ausencia de estas señales, basándose únicamente en su entorno físico, por lo que diseñaron un experimento para averiguarlo.
Colocaron muestras de P. polycephalum en placas de Petri, en un gel de agar simple. En un lado del plato, se colocó un único disco de vidrio pequeño. En el otro, se colocaron juntos tres discos de vidrio, uno al lado del otro. Los platos se colocaron en una habitación oscura, la configuración de luz preferida del moho de lodo, y se dejaron a su suerte.

Durante las primeras 12 horas aproximadamente, P. polycephalum creció uniformemente en todas las direcciones. Luego, en la marca de las 24 horas, el 70 por ciento de las muestras habían crecido hacia los tres discos en lugar del uno.
La experimentación adicional reveló aún más rarezas. Cuando los tres discos se apilaron uno encima del otro, en lugar de uno al lado del otro, el moho de lodo perdió su preferencia y creció hacia un lado u otro aproximadamente a la misma velocidad. Esto parecía sugerir que no era solo la masa la que causaba la preferencia del moho por los tres discos uno al lado del otro.
El factor adicional fue revelado por modelos informáticos. Cuando se colocan uno al lado del otro en el gel de agar elástico, los tres discos deforman el gel de manera diferente que cuando se colocan en una pila, al igual que tres pesos colocados uno al lado del otro en un trampolín causarán un patrón de tensión diferente al que tendría un peso apilado.
Este patrón de tensión en el gel de agar, determinó el equipo, es hacia lo que se mueve P. polycephalum .
“Imagina que estás conduciendo por la autopista de noche y buscas una ciudad en la que detenerte. Ves dos arreglos diferentes de luz en el horizonte: un único punto brillante y un grupo de puntos menos brillantes. Aunque el único punto es más brillante, el grupo de puntos ilumina un área más amplia por lo que es más probable que indique una ciudad “, dijo el ingeniero Richard Novak del Instituto Wyss.
“Los patrones de luz en este ejemplo son análogos a los patrones de tensión mecánica producidos por diferentes disposiciones de masa en nuestro modelo”, agregó.
Lo anterior generó una pregunta crucial: Sabiendo que moho de lodo no tiene cerebro o sistema nervioso ¿cómo es capaz de detectar este patrón de tensión? La respuesta tiene que ver con el movimiento y la comunicación interna del organismo.
El citoplasma dentro de P. polycephalum no es estático, sino que se mueve en pulsos. Las paredes de sus venas se contraen para actuar como una bomba peristáltica, empujando el fluido de una región a otra. Otros animales, como los mamíferos, tienen moléculas llamadas proteínas TRP en sus membranas celulares que pueden detectar el estiramiento.
Entonces, los investigadores decidieron darle a P. polycephalum un bloqueador de TRP para ver qué pasaba.
Efectivamente, el protista perdió su capacidad de discernir entre un disco de vidrio y tres discos de vidrio uno al lado del otro. En una nueva prueba, el 71 por ciento de las muestras se movieron hacia ambos lados de la placa de Petri. Esto sugiere que algo como las proteínas TRP están en juego dentro de P. polycephalum .
“Nuestro descubrimiento del uso de la biomecánica de este moho de lodo para sondear y reaccionar a su entorno circundante subraya cuán temprano esta capacidad evolucionó en los organismos vivos y cuán estrechamente relacionados están la inteligencia, el comportamiento y la morfogénesis”, dijo el biólogo Mike Levin del Instituto Wyss.
“Este trabajo en P. polycephalum ofrece un nuevo modelo para explorar las formas en que la evolución utiliza la física para implementar la cognición primitiva que impulsa la forma y la función”, concluyó el experto.
SEGUIR LEYENDO
Últimas Noticias
Científicos hallan hielo seco alrededor de una nebulosa en el espacio: qué revela sobre las estrellas
A 3.400 años luz de la Tierra, lograron identificar dióxido de carbono congelado en un denso anillo de polvo sometido a temperaturas extremas

Científicos estudian el impacto de rayos cósmicos: claves para proteger a astronautas en misiones espaciales
La nueva infraestructura científica desarrollada en Alemania brinda herramientas precisas para estudiar los efectos sobre organismos y materiales fuera de la órbita baja terrestre

Guardianes del clima en peligro: advierten sobre la pérdida acelerada de manglares por el cambio climático
Recientes hallazgos científicos presentan herramientas para medir y acelerar la restauración de un ecosistema esencial, cuya degradación compromete su función como defensa natural

El misterio del oro: científicos revelan cómo se forman los elementos más valiosos del universo
Una colaboración internacional permitió identificar los pasos ocultos en la formación de sustancias fundamentales para la vida y la industria. Cómo este avance logró resolver una incógnita histórica de la física

¿Por qué los mosquitos podrían ser la clave para descifrar la historia perdida de la humanidad?
Una investigación internacional muestra que el cambio de comportamiento en estos insectos puede iluminar capítulos olvidados y ofrecer nuevas herramientas para la paleoantropología


